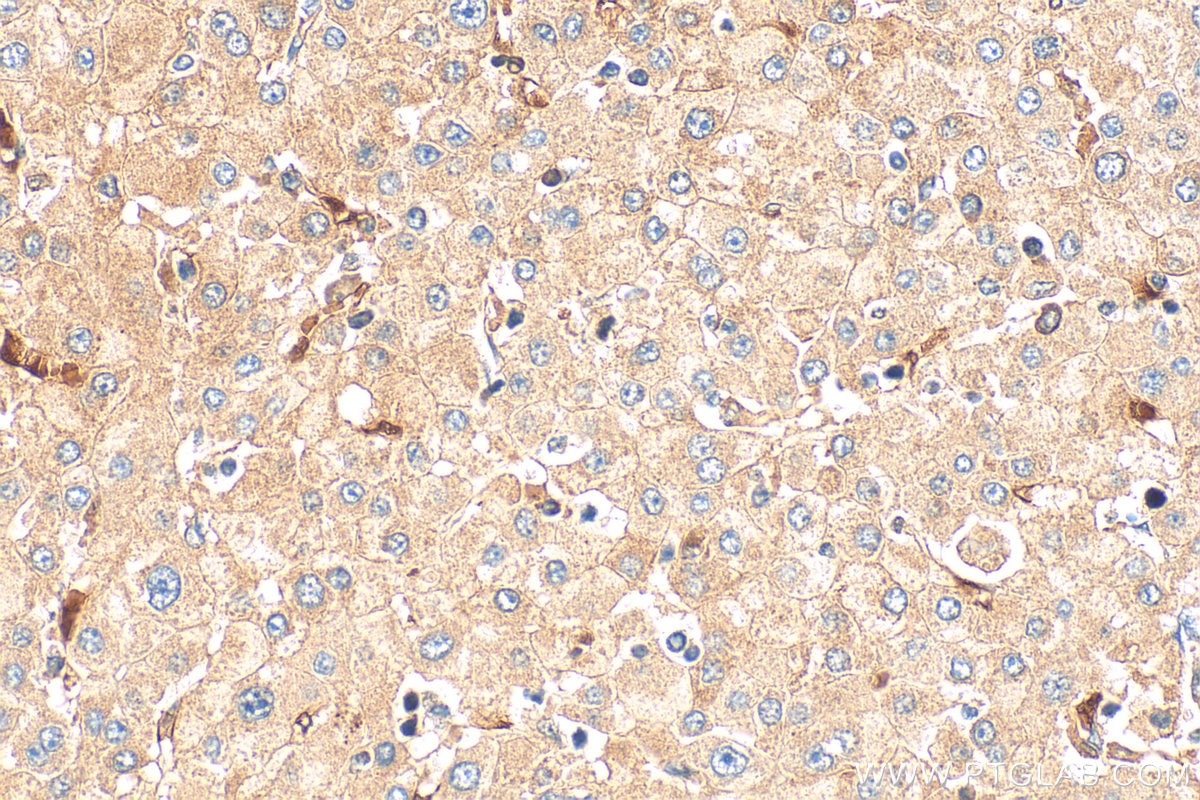
Immunohistochemistry (IHC) staining of human liver cancer tissue using PERK/EIF2AK3 Polyclonal antibody (24390-1-AP)

Validation Data Gallery
Tested Applications
| Positive WB detected in | HeLa cells, HepG2 cells, MCF-7 cells |
| Positive IHC detected in | human liver cancer tissue Note: suggested antigen retrieval with TE buffer pH 9.0; (*) Alternatively, antigen retrieval may be performed with citrate buffer pH 6.0 |
| Positive FC (Intra) detected in | HeLa cells |
Recommended dilution
| Application | Dilution |
|---|---|
| Western Blot (WB) | WB : 1:500-1:3000 |
| Immunohistochemistry (IHC) | IHC : 1:300-1:1200 |
| Flow Cytometry (FC) (INTRA) | FC (INTRA) : 0.40 ug per 10^6 cells in a 100 µl suspension |
| It is recommended that this reagent should be titrated in each testing system to obtain optimal results. | |
| Sample-dependent, Check data in validation data gallery. | |
Published Applications
| KD/KO | See 4 publications below |
| WB | See 129 publications below |
| IHC | See 7 publications below |
| IF | See 1 publications below |
| IP | See 1 publications below |
Product Information
24390-1-AP targets PERK/EIF2AK3 in WB, IHC, IF, FC (Intra), IP, ELISA applications and shows reactivity with human samples.
| Tested Reactivity | human |
| Cited Reactivity | human, mouse, rat, pig, chicken, bovine, sheep |
| Host / Isotype | Rabbit / IgG |
| Class | Polyclonal |
| Type | Antibody |
| Immunogen |
CatNo: Ag18254 Product name: Recombinant human EIF2AK3 protein Source: e coli.-derived, PET28a Tag: 6*His Domain: 767-1116 aa of BC126354 Sequence: TDCDVEDGTMDGNDEGHSFELCPSEASPYVRSRERTSSSIVFEDSGCDNASSKEEPKTNRLHIGNHCANKLTAFKPTSSKSSSEATLSISPPRPTTLSLDLTKNTTEKLQPSSPKVYLYIQMQLCRKENLKDWMNGRCTIEERERSVCLHIFLQIAEAVEFLHSKGLMHRDLKPSNIFFTMDDVVKVGDFGLVTAMDQDEEEQTVLTPMPAYARHTGQVGTKLYMSPEQIHGNSYSHKVDIFSLGLILFELLYPFSTQMERVRTLTDVRNLKFPPLFTQKYPCEYVMVQDMLSPSPMERPEAINIIENAVFEDLDFPGKTVLRQRSRSLSSSGTKHSRQSNNSHSPLPSN 相同性解析による交差性が予測される生物種 |
| Full Name | eukaryotic translation initiation factor 2-alpha kinase 3 |
| Calculated molecular weight | 1116 aa, 125 kDa |
| Observed molecular weight | 140 kDa |
| GenBank accession number | BC126354 |
| Gene Symbol | PERK |
| Gene ID (NCBI) | 9451 |
| RRID | AB_2879521 |
| Conjugate | Unconjugated |
| Form | |
| Form | Liquid |
| Purification Method | Antigen affinity purification |
| UNIPROT ID | Q9NZJ5 |
| Storage Buffer | PBS with 0.02% sodium azide and 50% glycerol{{ptg:BufferTemp}}7.3 |
| Storage Conditions | Store at -20°C. Stable for one year after shipment. Aliquoting is unnecessary for -20oC storage. |
Background Information
PERK, also named as EIF2AK3 or PEK, belongs to the protein kinase superfamily, Ser/Thr protein kinase family and GCN2 subfamily. It acts as a metabolic-stress sensing protein kinase that phosphorylates the alpha subunit of eukaryotic translation initiation factor 2 (EIF2S1/eIF-2-alpha) in response to various stress conditions. PERK and EIF2AK4 also have a functional role on regulating translation under non-stressed conditions, apart from their long established roles as stress kinases (PMID: 21638082). Defects in EIF2AK3 are the cause of Wolcott-Rallison syndrome (WRS). The molecular mass of PERK is 125 kDa and can be detected as 140 kDa or 170kDa due to some modifications such as glycosylation and phosphorylation (PMID: 20851775, 24371088, 21703327).
Protocols
| Product Specific Protocols | |
|---|---|
| FC protocol for PERK/EIF2AK3 antibody 24390-1-AP | Download protocol |
| IHC protocol for PERK/EIF2AK3 antibody 24390-1-AP | Download protocol |
| WB protocol for PERK/EIF2AK3 antibody 24390-1-AP | Download protocol |
| Standard Protocols | |
|---|---|
| Click here to view our Standard Protocols |
Publications
| Species | Application | Title |
|---|---|---|
Nat Commun Activation of GCN2/ATF4 signals in amygdalar PKC-δ neurons promotes WAT browning under leucine deprivation. | ||
J Adv Res Postantibiotic leukocyte enhancement-mediated reduction of intracellular bacteria by macrophages | ||
Autophagy Cannabidiol inhibits human glioma by induction of lethal mitophagy through activating TRPV4. | ||
Autophagy Inhibition of USP14 influences alphaherpesvirus proliferation by degrading viral VP16 protein via ER stress-triggered selective autophagy. | ||
Br J Pharmacol Substitution of the SERCA2 Cys(674) reactive thiol accelerates atherosclerosis by inducing endoplasmic reticulum stress and inflammation |